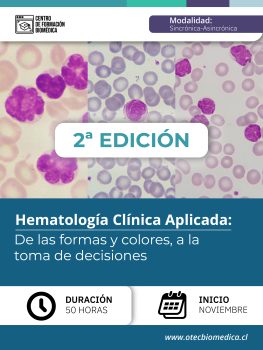

CUPOS AGOTADOS, MANTENTE ATENTO A PRÓXIMAS VERSIONES
Fortalecer competencias clínicas y analíticas en hematología, con énfasis en el estudio morfológico y la integración de datos del hemograma para la toma de decisiones diagnósticas en el laboratorio clínico.
Interpretar morfología celular en sangre periférica desde una perspectiva clínica.
Aplicar técnicas tintoriales, preanalíticas y de microscopía con estándares de calidad.
Identificar alteraciones en las tres series hematológicas: eritrocítica, leucocitaria y plaquetaria.
Correlacionar hallazgos microscópicos con resultados de laboratorio y datos clínicos.
Analizar casos clínicos simulados o reales mediante pensamiento crítico y trabajo colaborativo.
Desarrollar habilidades en redacción técnica, control de calidad e introducción a metodologías Seis Sigma.
Si deseas saber más del curso, accede a nuestro BROCHURE aquí:
[BROCHURE]Hematología Clínica Aplicada
Programa Curso Hematologia Clínica Aplicada
En caso de consultas, contáctanos a través de nuestra página o a nuestro correo contacto@otec.growth4u.cl
El Centro de Formación Biomédica se reserva el derecho de suspender la apertura del programa si no cuenta con el mínimo de estudiantes requeridos.